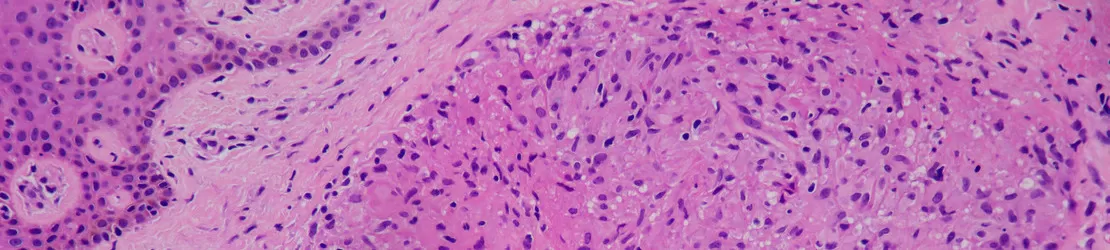
imagine a sarcoidozei pielii la microscop

Despre sarcoidoză
Sarcoidoza este o afecțiune care face ca sistemul imunitar să reacționeze excesiv și să producă noduli numiți și granuloame. În funcție de locație și dimensiune, granuloamele pot provoca simptome ușoare, până la severe. În unele cazuri, acești noduli se pot transforma în fibroză, cauzând cicatrici permanente.
Granuloamele pot apărea aproape oriunde în corp dar cel mai frecvent se găsesc în plămâni sau în ganglionii limfatici. De asemenea, este posibil să fie însoţiţi de semne vizibile de granuloame pe piele, la ochi sau pe fibrele musculare.
Un granulom este o zonă de inflamație cauzată de sistemul imunitar, alcătuit dintr-un grup de globule albe din sânge care au fost separate de restul corpului, pentru a încerca să protejeze organismul de ceva ce sistemul imunitar crede că este dăunător. Granuloamele sunt înconjurate de țesut dens, fibros, ceea ce le face vizibile, nodulare şi dureroase.
Sarcoidoza poate afecta pe oricine dar este mai frecvent întâlnită la persoanele de culoare şi la cele de sex feminin. Cele mai multe cazuri sunt diagnosticate între 25 și 40 de ani.
Deși nu s-a stabilit clar o legătură genetică, riscul de a dezvolta sarcoidoză pare să fie mai mare pentru pacienții care au o rudă biologică de gradul I (părinte, copil sau frate) care a fost diagnosticată cu sarcoidoză.
Sarcoidoza este considerată o boală rară, iar severitatea afecțiunii diferă de la persoană la persoană. Pentru majoritatea oamenilor, este o afecțiune temporară care dispare de la sine sau cu ajutorul tratamentului. Pentru unii pacienți, însă, este o boală cronică care provoacă daune permanente.
La aproximativ două treimi dintre persoanele diagnosticate cu sarcoidoză, boala va intra în remisie în doi până la trei ani de la debutul bolii. Sindromul Löfgren, care este o formă acută a sarcoidozei, are un prognostic deosebit de bun, majoritatea cazurilor fiind considerate vindecabile în șase luni până la doi ani.
Majoritatea persoanelor care manifestă sarcoidoză sunt susceptibile de forma cronică a bolii după trei ani de la debut. Doar aproximativ 10% până la 20% dintre cei cu sarcoidoză cronică vor rămâne cu leziuni permanente ale organelor. Cea mai frecventă complicație a sarcoidozei este cicatricea pulmonară.
Sarcoidoza poate fi fatală doar în 1% - 5% dintre cazuri.
Cauze
Cercetările sugerează că boala este determinată de o combinație dintre factori genetici și factori de mediu, dar cauza exactă a sarcoidozei este necunoscută. Studiile au arătat că anumite persoane prezintă un risc mai mare ca sistemul lor imunitar să reacționeze exagerat la anumiți factori declanșatori (antigeni), cum ar fi bacterii și virusuri.
Deși implică sistemul imunitar ca factor declanșator, sarcoidoza nu este considerată o tulburare autoimună.
Deoarece nu există dovezi clare în legătură cu ce combinație de gene și declanșatori provoacă sarcoidoza, este imposibil de prezis cine este predispus să dezvolte boala.
Factori de risc
Deși oricine poate dezvolta sarcoidoză, există și factori care pot crește riscul dezvoltării bolii:
- vârsta și sexul - sarcoidoza poate apărea la orice vârstă, dar cel mai adesea debutează între 20 și 60 de ani. Femeile sunt puțin mai susceptibile de a dezvolta boala;
- rasă - persoanele de origine africană și cele de origine nord-europeană au o incidență mai mare a sarcoidozei. Afro-americanii sunt mai susceptibili de a avea afectate și alte organe, împreună cu plămânii;
- anumite profesii - persoanele care lucrează cu substanţe ce produc inflamaţie prezintă un risc crescut;
- istoric familial - dacă cineva din familie a avut sarcoidoză, riscul este cu atât mai mare.
Simptome
Simptomele sarcoidozei depind de locul în care se formează granuloamele din corp. Majoritatea persoanelor cu sarcoidoză manifestă simptome pulmonare, dar pot exista semne și la nivelul pielii, ochilor, articulațiilor și aproape în orice altă parte a corpului. De asemenea, boala se poate manifesta fie cu senzație generală de rău, fie fără niciun fel de simptom.
Simptomele generale ale sarcoidozei sunt:
- febră;
- oboseală;
- dureri articulare;
- dureri musculare sau slăbiciune;
- transpirații nocturne;
- noduli limfatici umflați;
- pierdere în greutate inexplicabilă;
- pietre la rinichi.
Simptomele sarcoidozei la plămâni includ:
- tuse;
- dificultăți de respirație (dispnee);
- dureri în piept;
- respiraţie şuierătoare.
Simptomele sarcoidozei la ochi includ:
- vedere încețoșată sau pierderea vederii (nevrita optică);
- durere oculară;
- ochi roșii sau umflați (uveită sau conjunctivită);
- sensibilitate la lumină.
Simptomele sarcoidozei care afectează pielea sunt:
- noduli sub piele, în jurul cicatricilor sau tatuajelor;
- pete deschise sau întunecate de piele;
- răni sau erupții cutanate, reliefate, roșiatice-violet, pe nas sau obraji (lupus pernio);
- umflături roșii, sensibile, pe tibie (eritem nodos).
Simptomele sarcoidozei care afectează inima sunt:
- dureri în piept;
- bătăi fluturate ale inimii (palpitații);
- bătăi neregulate ale inimii (aritmie);
- insuficiență cardiacă;
- dificultăți de respirație.
Simptomele sarcoidozei sistemului nervos includ:
- sete crescută și urinat în cantități mari (diabet insipid);
- mușchii faciali slabi sau paralizați (paralizia lui Bell);
- dureri de cap;
- convulsii.
Sarcoidoza pulmonară, cea mai frecventă afecțiune, are mai multe etape, numite sistemul de clasificare Siltzbach.
Este important de știut că aceste etape nu sunt neapărat un indicator al severității afecțiunii și sunt marcate în special prin aspectul plămânilor, evidențiat la o radiografie toracică; ele descriu, în principal, locul unde sunt localizate granuloamele.
Un pacient cu sarcoidoză poate fi plasat între stadii sau poate manifesta o dispariție completă a granuloamelor. Singura etapă care este considerată ireversibilă este etapa a patra, în care afectarea pulmonară este permanentă.
- Etapa 0: radiografia nu arată nicio sarcoidoză pulmonară, plămânii și ganglionii limfatici apar normali la investigație.
- Etapa 1: apar granuloame numai în ganglionii limfatici.
- Etapa 2: apar granuloame în ganglionii limfatici și plămâni.
- Etapa 3: apar granuloame numai în plămâni.
- Etapa 4: radiografia arată fibroză pulmonară sau cicatrici permanente ale plămânilor.
Diagnosticare
Sarcoidoza este, de obicei, diagnosticată printr-o combinație de examen fizic, imagistică (radiografie toracică) și biopsie a granuloamelor suspectate. Deoarece sarcoidoza poate arăta ca alte afecțiuni, medicul specialist poate efectua teste suplimentare pentru a exclude alte boli.
Medicul specialist poate comanda și alte investigații pe baza semnelor și simptomelor relevate la examenul fizic și ca urmare a istoricului medical.
- teste imagistice: se folosesc aparate speciale pentru a fotografia structurile din interiorul corpului. Medicul specialist va recomanda radiografii toracice, tomografii sau RMN;
- biopsii: pot fi efectuate în multe moduri diferite, în funcție de locul în care apar granuloamele. Biopsiile de piele, conjunctive (ochi) și cele din ganglionii limfatici pot fi neinvazive sau minim invazive.
Procedurile mai complexe presupun examinarea țesutului din plămâni. Aceste proceduri includ:
- aspirația transbronșică, realizată cu ac fin, ghidată endobronșic, cu ultrasunete;
- biopsie bronhoscopică transbronșică;
- mediastinoscopia.
Alte teste pentru sarcoidoză includ:
- teste funcționale pulmonare - teste neinvazive, care măsoară cât de bine funcționează plămânii;
- teste de laborator - teste de sânge sau urină, folosite pentru a vedea cât de bine funcționează ficatul, rinichii și alte organe;
- electrocardiograma (EKG) - test de rutină, care verifică activitatea electrică a inimii;
- imagistica nucleară - scanările PET și scanările cu galiu folosesc o cantitate mică de material radioactiv injectat într-o venă, pentru a evidenția inflamația din corp;
- derivat proteic purificat - un test cutanat simplu, care poate diagnostica sau exclude tuberculoza care, uneori, este confundată cu sarcoidoza;
- examinare cu lampa cu fantă - specialistul examinează interiorul ochiului pentru a detecta problemele cauzate de sarcoidoză.
Tratament
Tratamentul pentru sarcoidoză are ca scop gestionarea simptomelor și prevenirea afectării organelor. Deoarece granuloamele sunt zone de inflamație, cauzate de celulele imune, sarcoidoza este, de obicei, tratată cu medicamente care modifică sau suprimă sistemul imunitar. Tratamentul depinde de localizarea granuloamelor.
Nu există un remediu specific pentru sarcoidoză și, dacă simptomele nu sunt deranjante sau nu pun viața în pericol, medicii aleg uneori să nu trateze imediat boala. Specialistul, cu sprijinul pacientului, va opta pentru monitorizarea simptomelor.
Medicamente folosite pentru a trata sarcoidoza au rolul de a reduce inflamația prin modificarea sau suprimarea sistemului imunitar:
- corticosteroizi - pot fi sub formă de pastile, inhalator sau creme topice, ce vor fi aplicate direct pe piele sau pe ochi;
- imunosupresoare - împiedică sistemului imunitar să provoace leziuni și inflamații ale organelor;
- anticorpi anti-factor de necroză tumorală-alfa (anticorpi anti-TNF-alfa) - cu scopul de a reduce inflamația, aceste medicamente sunt administrate prin perfuzie venoasă, sub supraveghere medicală;
- medicamente antiinflamatoare nesteroidiene (AINS) - ele pot ameliora temporar simptomele cauzate de inflamație dar nu sunt prescrise pentru utilizare pe termen lung.
Ameliorarea simptomelor după începerea tratamentului pentru sarcoidoză poate dura de la câteva săptămâni până la câteva luni. Medicul specialist va monitoriza pacientul și poate efectua din nou teste, pentru a vedea dacă tratamentul funcționează.
Unele cercetări sugerează că anumite diete pot reduce inflamația din organism. Consumul de alimente pe bază de plante, cum ar fi fructele și legumele, limitarea consumului de carne și brânză și evitarea zahărului și a carbohidraților ar putea ajuta la îmbunătățirea simptomelor sarcoidozei. Consultați-vă cu medicul specialist pneumolog înainte de a începe orice nouă dietă.
Complicații
Tratamentul cu corticosteroizi crește riscul de îmbolnăvire cu o boală infecțioasă și poate provoca o serie de reacții adverse, inclusiv:
- creștere excesivă în greutate;
- insomnie;
- acnee;
- diabet, la persoanele susceptibile;
- tensiune arterială crescută;
- glaucom;
- cataractă;
- osteoporoză;
- depresie și iritabilitate emoțională;
- echimoze ale pielii.
Din acest motiv, medicii recomandă utilizarea medicamentelor pentru a trata sarcoidoza doar dacă beneficiile depășesc riscurile aferente administrării.
Prevenție
Deoarece nu există dovezi documentate ale factorilor care cauzează sarcoidoza, nu există nicio modalitate de a o preveni sau de a reduce riscul apariției bolii. Prin respectarea schemei de tratament prescrisă de medicul specialist poate fi redus doar riscul de afectare a organelor, provocat de prezența granuloamelor.
Bibliografie
- NHS Choices. Sarcoidosis. 2024, www.nhs.uk/conditions/sarcoidosis/
- “Sarcoidosis - Symptoms and Causes.” Mayo Clinic, 2019, www.mayoclinic.org/diseases-conditions/sarcoidosis/symptoms-causes/syc-20350358
- Painter, Kim. “Sarcoidosis.” WebMD, WebMD, 28 Apr. 2005, www.webmd.com/lung/arthritis-sarcoidosis
Echipa medicală - Pneumologie și Dermatovenerologie
Solicită o programare
Alege opțiunea de a te programa online, simplu și rapid, prin intermediul formularului de programare.